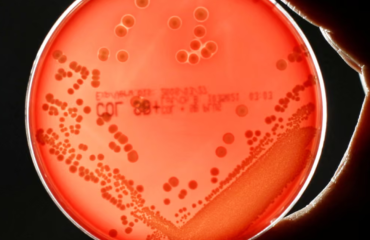
Superbugs could kill millions and trigger $2 trillion economic meltdown by 2050

Norway’s Massive Piggy Bank Just Ditched Fossil Fuels: What Happens When Oil Money Walks Away? So, picture this. You build an absolutely enormous pile of cash – we’re talking trillions – mostly by selling oil and gas. It’s the biggest single owner of stocks on the entire planet. Then, you decide, “You know what? WeNorway’s Sovereign Wealth Fund Divests From Fossil Fuels Amid Climate Pressures
The Looming Threat of Antimicrobial Resistance By 2050, unchecked antimicrobial resistance (AMR) could claim millions of lives annually. Superbugs might cost the global economy a staggering $2 trillion each year, according to The Centre for Global Development. A report backed by the UK government, cautions of a $1.7 trillion annual GDP depletion over 25 yearsSuperbugs Could Lead to Millions of Deaths and a $2 Trillion Economic Crisis by 2050